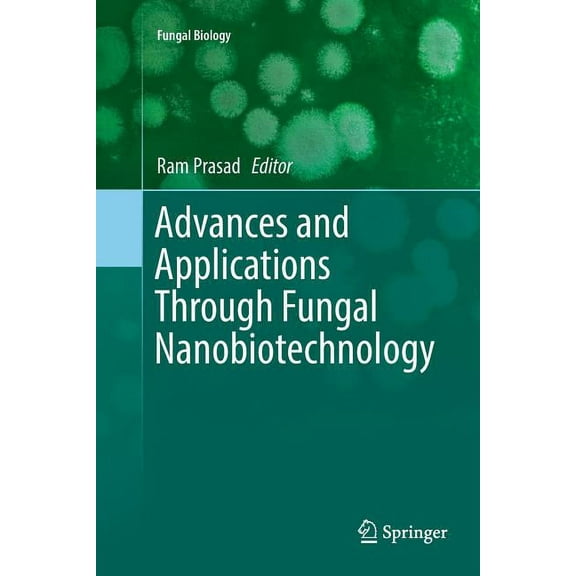
Fungal Biology Advances and Applications Through Fungal Nanobiotechnology, (Paperback)

Secaucus(14)
Uses item details. Price when purchased online
The Wrens- Secaucus -BF21 $41.56

$4156
current price $41.56The Wrens- Secaucus -BF21
Secaucus New Jersey City Of Birth Hometown Roots Souvenir Gift TShirt,for men and women up to 5XL From $17.50

8 options
Available in additional 8 optionsFrom$1750
Secaucus New Jersey City Of Birth Hometown Roots Souvenir Gift TShirt,for men and women up to 5XL
Saint Catherine of Secaucus, (Paperback) $16.99

$1699
current price $16.99Saint Catherine of Secaucus, (Paperback)
Save with
Jersey Shore Mike In Secaucus Funny G7195 Phone Case for iPhone17 16 15 14 13 12 11 Pro Max

9 options
Available in additional 9 optionsJersey Shore Mike In Secaucus Funny G7195 Phone Case for iPhone17 16 15 14 13 12 11 Pro Max
Return of the Secaucus 7 Movie Poster (11 x 17) - Item # MOVIE7706 $14.99

$1499
current price $14.99Return of the Secaucus 7 Movie Poster (11 x 17) - Item # MOVIE7706
Saint Catherine of Secaucus, (Hardcover) $25.19

$2519
current price $25.19Saint Catherine of Secaucus, (Hardcover)
Save with
Secaucus New Jersey Keepsakes Souvenir Vinyl Sticker – Destination Travel Keepsake Collectible (3-Inches Wide) From $4.99

3 options
Available in additional 3 optionsFrom$499
Secaucus New Jersey Keepsakes Souvenir Vinyl Sticker – Destination Travel Keepsake Collectible (3-Inches Wide)
Posterazzi MOVAH5696 Return of the Secaucus 7 Movie Poster - 27 x 40 in. $20.00

$2000
current price $20.00Posterazzi MOVAH5696 Return of the Secaucus 7 Movie Poster - 27 x 40 in.
Calvin Klein Men's Slim Straight Jean ( Secaucus Hs, 40W x 30L) $49.99

$4999
current price $49.99Calvin Klein Men's Slim Straight Jean ( Secaucus Hs, 40W x 30L)
Being Secaucus, (Paperback) $14.99

$1499
current price $14.99Being Secaucus, (Paperback)
Save with
Calvin Klein Men's Slim Straight Jean ( Secaucus Hs, 40W x 34L) $69.99

$6999
current price $69.99Calvin Klein Men's Slim Straight Jean ( Secaucus Hs, 40W x 34L)
Other options to consider(94)
Jersey Boys Multi Signed Autograph 27X40 Poster Young Piazza Bergen Lomenda JSA $362.99

$36299
current price $362.99Jersey Boys Multi Signed Autograph 27X40 Poster Young Piazza Bergen Lomenda JSA
Unisex GameDay Greats #1 Black South Carolina Gamecocks Lightweight Basketball Jersey

7 options
Available in additional 7 optionsUnisex GameDay Greats #1 Black South Carolina Gamecocks Lightweight Basketball Jersey
Chapman & Hall/CRC Texts in Statistical Applied Statistics: Handbook of GENSTAT Analysis, (Hardcover) $72.73 Was $81.41

Now$7273
current price Now $72.73, Was $81.41$81.41
Chapman & Hall/CRC Texts in Statistical Applied Statistics: Handbook of GENSTAT Analysis, (Hardcover)
Save with
Historic County Map - Hudson Union Essex Counties New Jersey - Beers 1872 - 34.5 x 23 - Vintage Wall Art From $40.95

From$4095
Historic County Map - Hudson Union Essex Counties New Jersey - Beers 1872 - 34.5 x 23 - Vintage Wall Art
Unisex GameDay Greats A'ja Wilson Black South Carolina Gamecocks Lightweight Basketball Alumni Jersey

7 options
Available in additional 7 optionsUnisex GameDay Greats A'ja Wilson Black South Carolina Gamecocks Lightweight Basketball Alumni Jersey
23 out of 5 Stars. 2 reviews
Biological and Medical Physics, Biomedic Physics with Illustrative Examples from Medicine and Biology: Mechanics, (Paperback) $54.99

$5499
current price $54.99Biological and Medical Physics, Biomedic Physics with Illustrative Examples from Medicine and Biology: Mechanics, (Paperback)
Save with
Bergen Norway Poster Colorful City Wall Art Bryggen Hanseatic Wharf Poster Travel Souvenir Art Poster Art Housewarming Gift Home Decor UNFRAMED Poster, Wall Art for Decor, Present, 8x12 From $19.99

4 options
Available in additional 4 optionsFrom$1999
Bergen Norway Poster Colorful City Wall Art Bryggen Hanseatic Wharf Poster Travel Souvenir Art Poster Art Housewarming Gift Home Decor UNFRAMED Poster, Wall Art for Decor, Present, 8x12
History Of The Land Titles In Hudson County, New Jersey, 1609-1871 (1872) (Hardcover) $53.75

$5375
current price $53.75History Of The Land Titles In Hudson County, New Jersey, 1609-1871 (1872) (Hardcover)
Youth GameDay Greats #1 White South Carolina Gamecocks Lightweight Baseball Fashion Jersey

5 options
Available in additional 5 optionsYouth GameDay Greats #1 White South Carolina Gamecocks Lightweight Baseball Fashion Jersey
Topics in Applied Physics Millimeter and Submillimeter Wave Spectroscopy of Solids, Book 74, (Paperback) $54.99

$5499
current price $54.99Topics in Applied Physics Millimeter and Submillimeter Wave Spectroscopy of Solids, Book 74, (Paperback)
Save with
Bergen Norway Bryggen Hanseatic Wharf Coastal City Art Print, Unframed Paper Poster 8x10in From $18.99

5 options
Available in additional 5 optionsFrom$1899
Bergen Norway Bryggen Hanseatic Wharf Coastal City Art Print, Unframed Paper Poster 8x10in
Hudson County To-day; its History, People, Trades, Commerce, Institutions and Industries (Hardcover) $32.00 Was $53.12

Now$3200
current price Now $32.00, Was $53.12$53.12
Hudson County To-day; its History, People, Trades, Commerce, Institutions and Industries (Hardcover)
Youth GameDay Greats White #1 South Carolina Gamecocks Lightweight Women's Soccer Jersey

2 options
Available in additional 2 optionsYouth GameDay Greats White #1 South Carolina Gamecocks Lightweight Women's Soccer Jersey
Acidic Deposition and Aquatic Ecosystems: Regional Case Studies, (Paperback) $91.38

$9138
current price $91.38Acidic Deposition and Aquatic Ecosystems: Regional Case Studies, (Paperback)
Save with
Historic County Map - Bergen Passaic Counties New Jersey - Beers 1872 - 34.56 x 23 - Vintage Wall Art From $40.95

From$4095
Historic County Map - Bergen Passaic Counties New Jersey - Beers 1872 - 34.56 x 23 - Vintage Wall Art
The Government of Hudson County, New Jersey (Paperback) $17.95

$1795
current price $17.95The Government of Hudson County, New Jersey (Paperback)
Save with
Men's GameDay Greats Green USC Upstate Spartans Lightweight Basketball Jersey

7 options
Available in additional 7 optionsMen's GameDay Greats Green USC Upstate Spartans Lightweight Basketball Jersey
Fungal Biology Advances and Applications Through Fungal Nanobiotechnology, (Paperback) $153.12
$15312
current price $153.12Fungal Biology Advances and Applications Through Fungal Nanobiotechnology, (Paperback)
Save with
Bergen Norway Poster Colorful City Wall Art Bryggen Hanseatic Wharf Poster Travel Souvenir Art Poster Art Housewarming Gift Home Decor, 8x12 UNFRAMED From $19.99

4 options
Available in additional 4 optionsFrom$1999
Bergen Norway Poster Colorful City Wall Art Bryggen Hanseatic Wharf Poster Travel Souvenir Art Poster Art Housewarming Gift Home Decor, 8x12 UNFRAMED
History Of Essex And Hudson Counties, New Jersey; Volume 1 (Hardcover) $46.95

$4695
current price $46.95History Of Essex And Hudson Counties, New Jersey; Volume 1 (Hardcover)
Save with
Gracie Abrams The Secret of Us Baseball Jersey Summer From $44.99

6 options
Available in additional 6 optionsFrom$4499
Gracie Abrams The Secret of Us Baseball Jersey Summer
Fungal Biology Advances and Applications Through Fungal Nanobiotechnology, (Hardcover) $143.76

$14376
current price $143.76Fungal Biology Advances and Applications Through Fungal Nanobiotechnology, (Hardcover)
Save with
Bergen County New Jersey Art, 1861 Vintage Map of Bergen County NJ History Wall Decor Gift, Old Bergen County NJ Map - 18" x 24" Black Framed Print From $69.99

4 options
Available in additional 4 optionsFrom$6999
Bergen County New Jersey Art, 1861 Vintage Map of Bergen County NJ History Wall Decor Gift, Old Bergen County NJ Map - 18" x 24" Black Framed Print
History of the County of Hudson, New Jersey: From its Earliest Settlement to the Present Time; Volume 2 (Paperback) $37.37

$3737
current price $37.37History of the County of Hudson, New Jersey: From its Earliest Settlement to the Present Time; Volume 2 (Paperback)
Save with
Popular in Secaucus
Related Products
Dravus Misguided Grounds Green Men's T-Shirt Heading No Where 1927 License Size Medium
Dravus Misguided Grounds Green Men's T-Shirt Heading No Where 1927 License Size Medium$15.52current price $15.52Normal is Boring - Men's T-Shirt Short Sleeve, up to Men Size 5XL - Netherlands Amsterdam
Normal is Boring - Men's T-Shirt Short Sleeve, up to Men Size 5XL - Netherlands Amsterdam$21.37current price $21.37American Flag T-shirt, Patroitic Shirts, Graphic T-shirts for Men - Heather Navy MH200PATRIOT S3 XL
American Flag T-shirt, Patroitic Shirts, Graphic T-shirts for Men - Heather Navy MH200PATRIOT S3 XL$17.99current price $17.99"In My Defense I Was Left Unsupervised" Funny Quote Men Royal Blue T-Shirt, Male x-Large
"In My Defense I Was Left Unsupervised" Funny Quote Men Royal Blue T-Shirt, Male x-Large$16.99current price $16.99Oh Lawd He Comin' Men T-Shirt, Male Small
Oh Lawd He Comin' Men T-Shirt, Male Small$10.50current price $10.50Vitruvian Man Mens T Shirt Yellow Haze LG
Vitruvian Man Mens T Shirt Yellow Haze LG$16.95current price $16.95I Heart East Los Angeles T-shirt - I Love East Los Angeles Tee Gift
I Heart East Los Angeles T-shirt - I Love East Los Angeles Tee Gift$23.95current price $23.95CafePress - Funny Polish Dupa White T Shirt - Men's White Classic Cotton T-Shirts
CafePress - Funny Polish Dupa White T Shirt - Men's White Classic Cotton T-Shirts$24.98current price $24.98I Am the American Dream T-Shirt - X-Large
I Am the American Dream T-Shirt - X-Large$16.95current price $16.95Mens What's A Matter U T Shirt Funny College Italian American Tee Graphic Tees
Mens What's A Matter U T Shirt Funny College Italian American Tee Graphic Tees$14.99current price $14.99













